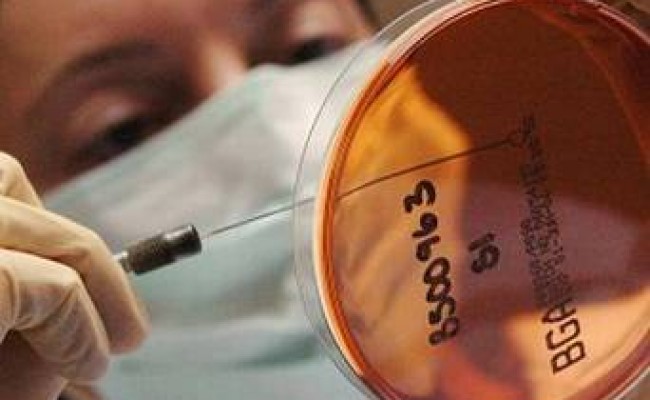

Organizația Mondială a Sănătății a declarat că investighează posibila izbucnire a unui focar de poliomelită în Siria, unde războiul civil a decimat infrastructura de sănătate publică, anunță CNN.
Organizația a spus duminică într-un comunicat că a primit un raport despre ”un grup de cazuri de paralizie acută flască (PAF)” descoperit în țară. Focarul a fost descoperit mai devreme luna aceasta în provincia sudică Deir Ezzor.
”Rezultatele inițiale de la laboratorul național de poliomelită din Damasc indică faptul că două dintre cazuri ar putea fi pozitive pentru polio, fiind așteptate rezultatele finale de la laboratorul regional de referință din Regiunea Estică Mediteraneană a OMS”, a spus organizația.
Poliovirusul sălbatic, care este foarte infecțios, a fost găsit ultima oară în Siria în 1999.
Ministrul sirian al Sănătății ”confirmă că tratează acest eveniment ca pe un focar activ de PAF, așteptând confirmarea finală de la laborator” și plănuiește un răspuns național de urgență.
Țările vecine plănuiesc și ele creșterea activităților de imunizare.
Un efort mundial de eradicare a bolii a avut ca rezultat reducerea apariției acesteia, care afectează în principal copiii mai mici de 5 ani, cu mai mult de 99% în ultimul sfert de secol, de la 350 000 de cazuri în 1988 la 233 raportate anul trecut, anunță OMS.
În 1988 boala se găsea constant în mai mult de 125 de țări; anul acesta, se găsește în doar trei- Afganistan, Nigeria și Pakistan.
Una din 200 de infectări are ca rezultat paralizia ireversibilă. Dintre cei care paralizează, 5-10% mor când muschii care ajută respirația sunt afectați.
Nu există niciun remediu pentru poliomelită, dar vaccinul, administrat de mai multe ori, poate proteja pe tot parcursul vieții.
În ciuda infrastructurii sănătății publice precare, India a reușit să stopeze poliomelita în 2011.